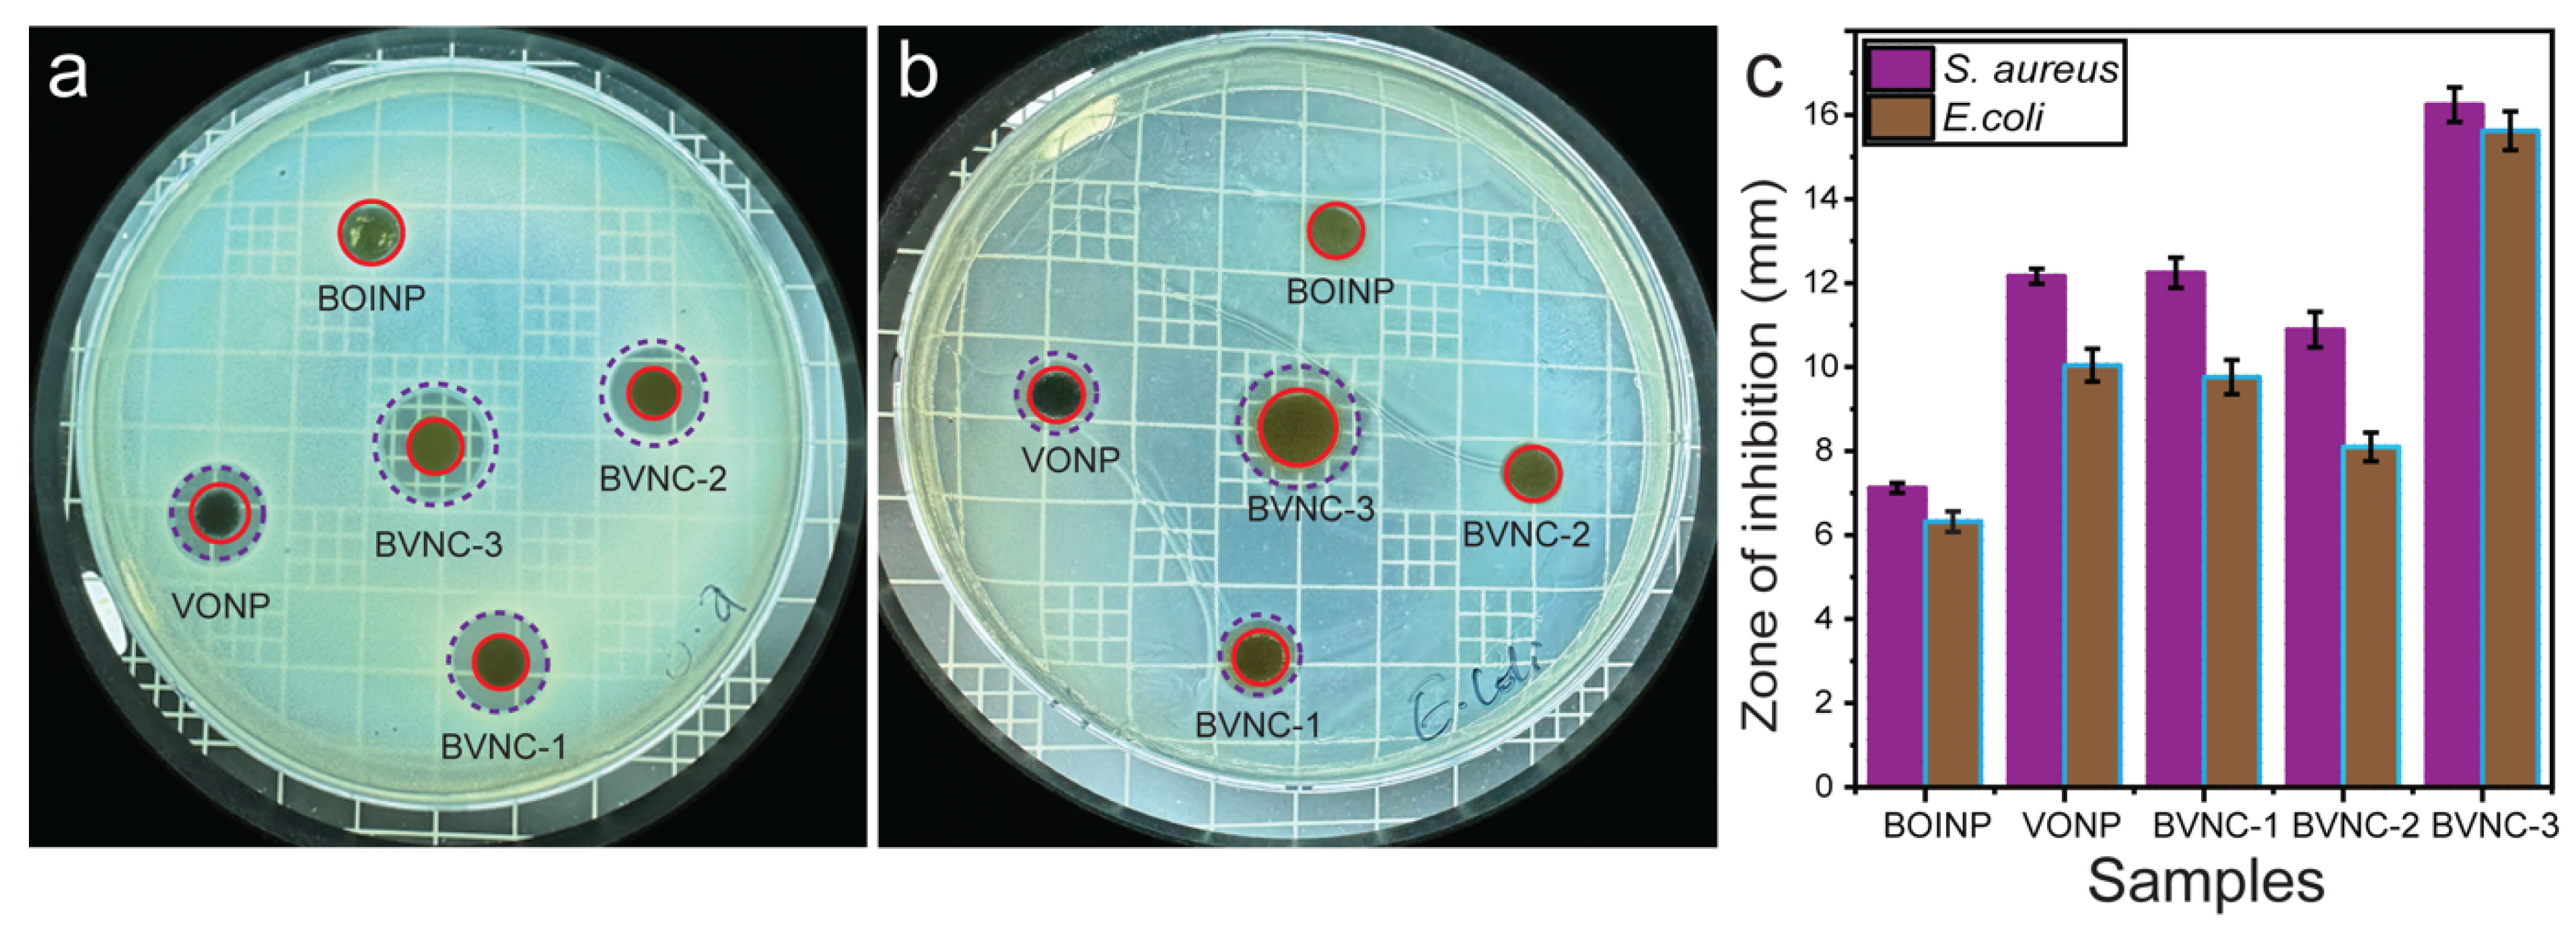
Molecules 30 02500 g009

Harnessing BiOI/V2O5 Nanocomposites: Advanced Bifunctional Catalysts for Visible-Light Driven Environmental Remediation and Antibacterial Activity
Abstract
1. Introduction
2. Results and Discussion
2.1. Morphological and Physicochemical Characterization
2.2. Optical Properties: Photoluminescence and Bandgap Evaluations
2.3. Adsorption and Photocatalytic Degradation Performance
2.4. Effect of Catalyst Dose, Pollutant Dose, and Reusability
2.5. Effect of Point of Zero Charge and pH
2.6. Active Charge Trapping Test
2.7. Proposed Photocatalytic Mechanism
2.8. Detection of Degradation Fragments via LC-MS
2.9. Bactericidal Activity
3. Experimental Section
3.1. Chemical Reagents
3.2. Synthesis of BiOI/V2O5 Nanocomposites
3.3. Synthesis of BiOI Nanoparticles and V2O5 Nanoparticles
3.4. Characterization
3.5. Photocatalytic Degradation
3.6. Reusability Assessment
3.7. Deduction of the Point of Zero Charge and pH Effects
3.8. Charge Trapping Experiments
3.9. Liquid Chromatography-Mass Spectroscopy (LC-MS) Analysis
3.10. Antibacterial Activity
4. Conclusions
Supplementary Materials
Author Contributions
Funding
Institutional Review Board Statement
Informed Consent Statement
Data Availability Statement
Conflicts of Interest
References
- Gyawali, N.; Lee, I.; Shrestha, S.; Acharya, S.; Zahid, A.; Kim, K.; Sapkota, K.P.; Hahn, J.R. MOF-derived in situ confinement of copper/copper oxide nanoparticles inside a carbon tube: A facile morphologically controlled synthesis strategy for superior visible-light-driven photocatalytic efficiency. Ind. Eng. Chem. Res. 2025, 64, 5212–5227. [Google Scholar] [CrossRef]
- Kishor, R.; Purchase, D.; Saratale, G.D.; Saratale, R.G.; Ferreira, L.F.R.; Bilal, M.; Chandra, R.; Bharagava, R.N. Ecotoxicological and health concerns of persistent coloring pollutants of textile industry wastewater and treatment approaches for environmental safety. J. Environ. Chem. Eng. 2021, 9, 105012. [Google Scholar] [CrossRef]
- Tan, K.A.; Morad, N.; Ooi, J.Q. Phytoremediation of methylene blue and methyl orange using Eichhornia crassipes. Int. J. Environ. Sci. Dev. 2016, 7, 724–728. [Google Scholar] [CrossRef]
- Nashim, A.; Parida, K. Novel Sm2Ti2O7/SmCrO3 heterojunction based composite photocatalyst for degradation of Rhodamine 6G dye. Chem. Eng. J. 2013, 215–216, 608–615. [Google Scholar] [CrossRef]
- Moussavi, G.; Pourakbar, M.; Shekoohiyan, S.; Satari, M. The photochemical decomposition and detoxification of bisphenol A in the VUV/H2O2 process: Degradation, mineralization, and cytotoxicity assessment. Chem. Eng. J. 2018, 331, 755–764. [Google Scholar] [CrossRef]
- Pouzaud, F.; Thierry-Mieg, M.; Burga, K.; Vérines-Jouin, L.; Fiore, K.; Beausoleil, C.; Michel, C.; Rousselle, C.; Pasquier, E. ANSES’s working group on endocrine disruptors, anses’s expert committee on chemicals covered by the reach and CLP regulations, concerns related to Ed-mediated effects of bisphenol A and their regulatory consideration. Mol. Cell. Endocrinol. 2018, 475, 92–106. [Google Scholar] [CrossRef]
- Jia, Y.; Ding, L.; Ren, P.; Zhong, M.; Ma, J.; Fan, X. Performances and mechanism of methyl orange and congo red adsorbed on the magnetic ion-exchange resin. J. Chem. Eng. Data 2020, 65, 725–736. [Google Scholar] [CrossRef]
- Li, M.; Li, J.-T.; Sun, H.-W. Decolorizing of azo dye Reactive red 24 aqueous solution using exfoliated graphite and H2O2 under ultrasound irradiation. Ultrason. Sonochem. 2008, 15, 717–723. [Google Scholar] [CrossRef]
- Crini, G.; Lichtfouse, E. Advantages and disadvantages of techniques used for wastewater treatment. Environ. Chem. Lett. 2019, 17, 145–155. [Google Scholar] [CrossRef]
- Natarajan, S.; Bajaj, H.C.; Tayade, R.J. Recent advances based on the synergetic effect of adsorption for removal of dyes from waste water using photocatalytic process. J. Environ. Sci. 2018, 65, 201–222. [Google Scholar] [CrossRef]
- Yang, Y.; Zhang, C.; Lai, C.; Zeng, G.; Huang, D.; Cheng, M.; Wang, J.; Chen, F.; Zhou, C.; Xiong, W. BiOX (X = Cl, Br, I) photocatalytic nanomaterials: Applications for fuels and environmental management. Adv. Colloid Interface Sci. 2018, 254, 76–93. [Google Scholar] [CrossRef] [PubMed]
- Yousefi, A.; Nezamzadeh-Ejhieh, A. Characterization of BiOCl/BiOI binary catalyst and its photocatalytic activity towards rifampin. J. Photochem. Photobiol. A Chem. 2022, 433, 114135. [Google Scholar] [CrossRef]
- Sun, N.; Zhou, M.; Ma, X.; Cheng, Z.; Wu, J.; Qi, Y.; Sun, Y.; Zhou, F.; Shen, Y.; Lu, S. Self-assembled spherical In2O3/BiOI heterojunctions for enhanced photocatalytic CO2 reduction activity. J. CO2 Util. 2022, 65, 102220. [Google Scholar] [CrossRef]
- Cheng, H.; Huang, B.; Dai, Y.; Qin, X.; Zhang, X. One-step synthesis of the nanostructured AgI/BiOI composites with highly enhanced visible-light photocatalytic performances. Langmuir 2010, 26, 6618–6624. [Google Scholar] [CrossRef]
- Liao, X.; Li, T.-T.; Ren, H.-T.; Zhang, X.; Shen, B.; Lin, J.-H.; Lou, C.-W. Construction of BiOI/TiO2 flexible and hierarchical S-scheme heterojunction nanofibers membranes for visible-light-driven photocatalytic pollutants degradation. Sci. Total Environ. 2022, 806, 150698. [Google Scholar] [CrossRef]
- Wang, J.-C.; Yao, H.-C.; Fan, Z.-Y.; Zhang, L.; Wang, J.-S.; Zang, S.-Q.; Li, Z.-J. Indirect Z-scheme BiOI/g-C3N4 photocatalysts with enhanced photoreduction CO2 activity under visible light irradiation. ACS Appl. Mater. Interfaces 2016, 8, 3765–3775. [Google Scholar] [CrossRef]
- Zhang, C.; Fei, W.; Wang, H.; Li, N.; Chen, D.; Xu, Q.; Li, H.; He, J.; Lu, J. p-n Heterojunction of BiOI/ZnO nanorod arrays for piezo-photocatalytic degradation of bisphenol A in water. J. Hazard. Mater. 2020, 399, 123109. [Google Scholar] [CrossRef]
- Niu, J.; Dai, P.; Wang, K.; Zhang, Z.; Zhang, Q.; Yao, B.; Yu, X. Microwave-assisted synthesis of high efficient α-Fe2O3/BiOI composites and its performance in photocatalytic degardation of organic pollutants. Adv. Powder Technol. 2020, 31, 2327–2336. [Google Scholar] [CrossRef]
- Su, J.; Zou, X.-X.; Li, G.-D.; Wei, X.; Yan, C.; Wang, Y.-N.; Zhao, J.; Zhou, L.-J.; Chen, J.-S. Macroporous V2O5−BiVO4 composites: Effect of heterojunction on the behavior of photogenerated charges. J. Phys. Chem. C 2011, 115, 8064–8071. [Google Scholar] [CrossRef]
- Selvam, P.S.S.; Chinnadurai, G.S.; Ganesan, D.; Kandan, V. Eggshell membrane-mediated V2O5/ZnO nanocomposite: Synthesis, characterization, antibacterial activity, minimum inhibitory concentration, and its mechanism. Appl. Phys. A 2020, 126, 893. [Google Scholar] [CrossRef]
- Aslam, M.; Ismail, I.M.; Almeelbi, T.; Salah, N.; Chandrasekaran, S.; Hameed, A. Enhanced photocatalytic activity of V2O5–ZnO composites for the mineralization of nitrophenols. Chemosphere 2014, 117, 115–123. [Google Scholar] [CrossRef] [PubMed]
- Hong, Y.; Jiang, Y.; Li, C.; Fan, W.; Yan, X.; Yan, M.; Shi, W. In-situ synthesis of direct solid-state Z-scheme V2O5/g-C3N4 heterojunctions with enhanced visible light efficiency in photocatalytic degradation of pollutants. Appl. Catal. B Environ. 2016, 180, 663–673. [Google Scholar] [CrossRef]
- Sadeghzadeh-Attar, A. Enhanced photocatalytic hydrogen evolution by novel Nb-doped SnO2/V2O5 heteronanostructures under visible light with simultaneous basic red 46 dye degradation. J. Asian Ceram. Soc. 2020, 8, 662–676. [Google Scholar] [CrossRef]
- Panchal, P.; Paul, D.R.; Sharma, A.; Hooda, D.; Yadav, R.; Meena, P.; Nehra, S. Phytoextract mediated ZnO/MgO nanocomposites for photocatalytic and antibacterial activities. J. Photochem. Photobiol. A Chem. 2019, 385, 112049. [Google Scholar] [CrossRef]
- Vouga, M.; Greub, G. Emerging bacterial pathogens: The past and beyond. Clin. Microbiol. Infect. 2016, 22, 12–21. [Google Scholar] [CrossRef]
- Mukhtar, F.; Munawar, T.; Nadeem, M.S.; Hasan, M.; Hussain, F.; Nawaz, M.A.; Iqbal, F. Multi metal oxide NiO-Fe2O3-CdO nanocomposite-synthesis, photocatalytic and antibacterial properties. Appl. Phys. A 2020, 126, 588. [Google Scholar] [CrossRef]
- Munawar, T.; Yasmeen, S.; Mukhtar, F.; Nadeem, M.S.; Mahmood, K.; Saif, M.S.; Hasan, M.; Ali, A.; Hussain, F.; Iqbal, F. Zn0.9Ce0.05M0.05O (M = Er, Y, V) nanocrystals: Structural and energy bandgap engineering of ZnO for enhancing photocatalytic and antibacterial activity. Ceram. Int. 2020, 46, 14369–14383. [Google Scholar] [CrossRef]
- Usharani, S.; Rajendran, V. Size controlled synthesis and characterization of V2O5/Al2O3 nanocomposites. Colloid Interface Sci. Commun. 2018, 24, 7–12. [Google Scholar] [CrossRef]
- Shireesha, K.; Chidurala, S.C. Impact of hybridization on specific capacitance in hybrid NiO/V2O5@graphene composites as advanced supercapacitor electrode materials. Appl. Surf. Sci. Adv. 2022, 12, 100329. [Google Scholar] [CrossRef]
- Zhang, T.; Wang, X.; Sun, Z.; Liang, Q.; Zhou, M.; Xu, S.; Li, Z.; Sun, D. Constructing Z-scheme based BiOI/CdS heterojunction with efficient visible-light photocatalytic dye degradation. Solid State Sci. 2020, 107, 106350. [Google Scholar] [CrossRef]
- Waseem, M.; Ahmad, A.; Sagir, M.; Younas, U.; Saeed, Z.; Pervaiz, M.; Ali, F.; Aljuwayid, A.M.; Habila, M.A.; Karri, R.R. Hydrothermal synthesis of V2O5/TiO2 decorated graphitic carbon nitride nanocomposite for biomolecule oxidation inhibition and dye degradation applications. Environ. Res. 2023, 234, 116440. [Google Scholar] [CrossRef] [PubMed]
- Reddy, K.H.; Martha, S.; Parida, K. Fabrication of novel p-BiOI/n-ZnTiO3 heterojunction for degradation of rhodamine 6G under visible light irradiation. Inorg. Chem. 2013, 52, 6390–6401. [Google Scholar] [CrossRef] [PubMed]
- Gyawali, N.; Kandel, R.; Lee, I.; Shrestha, S.; Pandey, A.; Akter, J.; Hahn, J.R. Silver decoration of Cr2O3 nanoparticles: Facile preparation of Cr2O3 nanoparticles and Ag–Cr2O3 nanocomposites and characterization of their antibacterial activity and ability to photocatalytically degrade organic wastes under visible light. J. Photochem. Photobiol. A Chem. 2023, 447, 115251. [Google Scholar] [CrossRef]
- Yadav, A.A.; Hunge, Y.M.; Kang, S.-W.; Fujishima, A.; Terashima, C. Enhanced photocatalytic degradation activity using the V2O5/RGO composite. Nanomaterials 2023, 13, 338. [Google Scholar] [CrossRef]
- Zhai, T.; Liu, H.; Li, H.; Fang, X.; Liao, M.; Li, L.; Zhou, H.; Koide, Y.; Bando, Y.; Golberg, D. Centimeter-long V2O5 nanowires: From synthesis to field-emission, electrochemical, electrical transport, and photoconductive properties. Adv. Mater. 2010, 22, 2547–2552. [Google Scholar] [CrossRef]
- Li, J.; Zhou, Q.; Yang, F.; Wu, L.; Li, W.; Ren, R.; Lv, Y. Uniform flower-like BiOBr/BiOI prepared by a new method: Visible-light photocatalytic degradation, influencing factors and degradation mechanism. New J. Chem. 2019, 43, 14829–14840. [Google Scholar] [CrossRef]
- Florez-Rios, J.F.; Santana-Aranda, M.A.; Quiñones-Galván, J.G.; Escobedo-Morales, A.; Chávez-Chávez, A.; Pérez-Centeno, A. Alternative Bi precursor effects on the structural, optical, morphological and photocatalytic properties of BiOI nanostructures. Mater. Res. Express 2020, 7, 015912. [Google Scholar] [CrossRef]
- Wang, J.; Yu, Z.; Wang, L.; Wang, B.; Liu, F.; Liang, X.; Sun, P.; Yan, X.; Chuai, X.; Lu, G. Improvement of NO2 sensing characteristic for mixed potential type gas sensor based on YSZ and Rh/Co3V2O8 sensing electrode. RSC Adv. 2017, 7, 49440–49445. [Google Scholar] [CrossRef]
- Huang, X.; Guo, Q.; Yan, B.; Liu, H.; Chen, K.; Wei, S.; Wu, Y.; Wang, L. Study on photocatalytic degradation of phenol by BiOI/Bi2WO6 layered heterojunction synthesized by hydrothermal method. J. Mol. Liq. 2021, 322, 114965. [Google Scholar] [CrossRef]
- Neupane, G.R.; Hari, P. Role of polyvinylpyrrolidone (PVP) on controlling the structural, optical, and electrical properties of vanadium pentoxide (V2O5) nanoparticles. ChemistrySelect 2020, 5, 11596–11607. [Google Scholar] [CrossRef]
- Shi, X.; Quan, S.; Yang, L.; Liu, C.; Shi, F. Anchoring Co3O4 on BiFeO3: Achieving high photocatalytic reduction in Cr(VI) and low cobalt leaching. J. Mater. Sci. 2019, 54, 12424–12436. [Google Scholar] [CrossRef]
- Makuła, P.; Pacia, M.; Macyk, W. How to correctly determine the band gap energy of modified semiconductor photocatalysts based on UV–vis spectra. J. Phys. Chem. Lett. 2018, 9, 6814–6817. [Google Scholar] [CrossRef] [PubMed]
- Lei, S.; Luo, R.; Li, H.; Chen, J.; Zhong, J.; Li, J. Ionic liquid assisted in-situ construction of S-scheme BiOI/Bi2WO6 heterojunctions with improved sunlight-driven photocatalytic performance. Inorg. Chem. Commun. 2020, 121, 108192. [Google Scholar] [CrossRef]
- Morante, N.; Monzillo, K.; Vaiano, V.; Kadirova, Z.C.; Sannino, D. Synthesis and Characterization of a novel sol–gel-derived Ni-doped TiO2 photocatalyst for rapid visible light-driven mineralization of paracetamol. Nanomaterials 2025, 15, 530. [Google Scholar] [CrossRef]
- Tolhurst, T.M.; Leedahl, B.; Andrews, J.L.; Banerjee, S.; Moewes, A. The electronic structure of ε′-V2O5: An expanded band gap in a double-layered polymorph with increased interlayer separation. J. Mater. Chem. A 2017, 5, 23919–23927. [Google Scholar] [CrossRef]
- Hernández-Laverde, M.; Morante, N.; Gutiérrez, B.L.; Murcia, J.J.; Monzillo, K.; Sannino, D.; Vaiano, V. Solar light elimination of bacteria, yeast and organic pollutants by effective photocatalysts based on Ag/Cr-TiO2 and Pd/Cr-TiO2. Nanomaterials 2024, 14, 1730. [Google Scholar] [CrossRef]
- Morante, N.; De Guglielmo, L.; Oliva, N.; Monzillo, K.; Femia, N.; Di Capua, G.; Vaiano, V.; Sannino, D. Influence of UV-A light modulation on phenol mineralization by TiO2 photocatalytic process coadjuvated with H2O2. Catalysts 2024, 14, 544. [Google Scholar] [CrossRef]
- Shrestha, S.; Sapkota, K.P.; Lee, I.; Islam, A.; Pandey, A.; Gyawali, N.; Akter, J.; Mohan, H.; Shin, T.; Jeong, S.; et al. Carbon-based ternary nanocomposite: Bullet type ZnO–SWCNT–CuO for substantial solar-driven photocatalytic decomposition of aqueous organic contaminants. Molecules 2022, 27, 8812. [Google Scholar] [CrossRef]
- Dai, D.; Qiu, J.; Xia, G.; Tang, Y.; Liu, Q.; Li, Y.; Fang, B.; Yao, J. Metal-Organic Framework templated Z-Scheme ZnIn2S4/Bi2S3 hierarchical heterojunction for photocatalytic H2O2 production from wastewater. Small 2024, 20, e2403268. [Google Scholar] [CrossRef]
- Fang, B.; Qiu, J.; Xia, G.; Wang, M.; Dai, D.; Tang, Y.; Li, Y.; Yao, J. Carboxylated cellulose-derived carbon mediated flower-like bismuth oxyhalides for efficient Cr(VI) reduction under visible light. J. Colloid Interface Sci. 2024, 678, 125–133. [Google Scholar] [CrossRef]
- Song, P.-Y.; Xu, M.; Zhang, W.-D. Sodium citrate-assisted anion exchange strategy for construction of Bi2O2CO3/BiOI photocatalysts. Mater. Res. Bull. 2015, 62, 88–95. [Google Scholar] [CrossRef]
- Xu, Y.; Schoonen, M.A. The absolute energy positions of conduction and valence bands of selected semiconducting minerals. Am. Miner. 2000, 85, 543–556. [Google Scholar] [CrossRef]
- Li, Y.; Qiu, J.; Xu, J.; Tang, Y.; Dai, D.; Xia, G.; Fang, B.; Yao, J. Ti-MOF-derived titanium oxide-modified carbon nitride: A Z-scheme heterostructure for the selective photocatalytic cleavage of lignin C–C bonds. J. Catal. 2025, 446, 116076. [Google Scholar] [CrossRef]
- Yan, T.; Liu, H.; Gao, P.; Sun, M.; Wei, Q.; Xu, W.; Wang, X.; Du, B. Facile synthesized highly active BiOI/Zn2GeO4 composites for the elimination of endocrine disrupter BPA under visible light irradiation. New J. Chem. 2015, 39, 3964–3972. [Google Scholar] [CrossRef]
- Li, H.; Jin, Z.; Sun, H.; Sun, L.; Li, Q.; Zhao, X.; Jia, C.-J.; Fan, W. Facile fabrication of p-BiOI/n-Zn2SnO4 heterostructures with highly enhanced visible light photocatalytic performances. Mater. Res. Bull. 2014, 55, 196–204. [Google Scholar] [CrossRef]
- Chai, B.; Wang, X. Enhanced visible light photocatalytic activity of BiOI/BiOCOOH composites synthesized via ion exchange strategy. RSC Adv. 2014, 5, 7589–7596. [Google Scholar] [CrossRef]
- Musarrat, N.; Fatima, M.; Batool, Z.; Imran, M.; Jabeen, Q.; Ahmad, H.E.; Manzoor, M.Z.; Abbas, S.M.; Saira, F.; Ihsan, M.U.; et al. In vivo toxicity evaluation and antibacterial assessment of vanadium doped Bi2Se3 synthesized by cost effective method. Mater. Chem. Phys. 2024, 325, 129686. [Google Scholar] [CrossRef]
- Godoy-Gallardo, M.; Eckhard, U.; Delgado, L.M.; de Roo Puente, Y.J.; Hoyos-Nogués, M.; Gil, F.J.; Perez, R.A. Antibacterial approaches in tissue engineering using metal ions and nanoparticles: From mechanisms to applications. Bioact. Mater. 2021, 6, 4470–4490. [Google Scholar] [CrossRef]
- Kim, H.; Lee, D.G. Contribution of SOS genes to H2O2-induced apoptosis-like death in Escherichia coli. Curr. Genet. 2021, 67, 969–980. [Google Scholar] [CrossRef]
- Borisov, V.B.; Siletsky, S.A.; Nastasi, M.R.; Forte, E. ROS defense systems and terminal oxidases in bacteria. Antioxidants 2021, 10, 839. [Google Scholar] [CrossRef]
- Rodríguez-Rojas, A.; Kim, J.J.; Johnston, P.R.; Makarova, O.; Eravci, M.; Weise, C.; Hengge, R.; Rolff, J. Non-lethal exposure to H2O2 boosts bacterial survival and evolvability against oxidative stress. PLoS Genet. 2020, 16, e1008649. [Google Scholar] [CrossRef] [PubMed]
- Jayaraj, S.K.; Sadishkumar, V.; Arun, T. Thangadurai, Enhanced photocatalytic activity of V2O5 nanorods for the photodegradation of organic dyes: A detailed understanding of the mechanism and their antibacterial activity. Mater. Sci. Semicond. Process. 2018, 85, 122–133. [Google Scholar] [CrossRef]
- Jalil, M.; Khan, M.; Mandal, S.; Chowdhury, F.U.Z.; Hossain, M.; Jana, D.; Alam, M.; Uddin, M. Impact of reaction temperatures on the particle size of V2O5 synthesized by facile hydrothermal technique and photocatalytic efficacy in dye degradation. AIP Adv. 2003, 13, 015010. [Google Scholar] [CrossRef]
- Mondal, M.; Dutta, H.; Pradhan, S. Enhanced photocatalysis performance of mechanosynthesized V2O5-TiO2 nanocomposite for wastewater treatment: Correlation of structure with photocatalytic performance. Mater. Chem. Phys. 2020, 248, 122947. [Google Scholar] [CrossRef]
- Xiao, W.; Su, Y.; Luo, J.; Jiang, L.; Wu, X.; Liu, Z.; Pang, H.; Zhang, Q.; Zhang, P. Flower-like hierarchical architecture of BiOI/ZnO pn junction composites with high-efficient visible-light photodegradation activities. Solid State Sci. 2020, 108, 106432. [Google Scholar] [CrossRef]
- Xu, H.Y.; Wang, W.S.; Li, B.; Zhang, L. Mechanism insights into the enhanced photocatalytic peroxydisulfate activation by Fe3O4/BiOI heterojunction. Mater. Sci. Eng. B 2023, 294, 116509. [Google Scholar] [CrossRef]
- Zhang, J.; Fu, J.; Wang, Z.; Cheng, B.; Dai, K.; Ho, W. Direct Z-scheme porous g-C3N4/BiOI heterojunction for enhanced visible-light photocatalytic activity. J. Alloys Compd. 2018, 766, 841–850. [Google Scholar] [CrossRef]
- Makhtar, S.N.N.M.; Yusof, N.; Fajrina, N.; Hairom, N.H.H.; Aziz, F.; Salleh, W.N.W. V2O5/CdS as nanocomposite catalyst for Congo red dye photocatalytic degradation under visible light. Mater. Today Proc. 2024, 96, 69–72. [Google Scholar] [CrossRef]
- Ahirrao, D.J.; Tambat, S.N.; Sonawane, S.S.; Alone, S.T.; Pathrikar, R.D. V2O5 Based Nanocomposites for the Adsorption and Photocatalytic Degradation of Methylene Blue Dye. Optik 2024, 303, 171732. [Google Scholar] [CrossRef]
- Saravanan, R.; Joicy, S.; Gupta, V.K.; Narayanan, V.; Stephen, A. Visible light-induced degradation of methylene blue using CeO2/V2O5 and CeO2/CuO catalysts. Mater. Sci. Eng. C 2013, 33, 4725–4731. [Google Scholar] [CrossRef]

Disclaimer/Publisher’s Note: The statements, opinions and data contained in all publications are solely those of the individual author(s) and contributor(s) and not of MDPI and/or the editor(s). MDPI and/or the editor(s) disclaim responsibility for any injury to people or property resulting from any ideas, methods, instructions or products referred to in the content. |
© 2025 by the authors. Licensee MDPI, Basel, Switzerland. This article is an open access article distributed under the terms and conditions of the Creative Commons Attribution (CC BY) license (https://creativecommons.org/licenses/by/4.0/).
Share and Cite
Pandey, A.; Gyawali, N.; Shrestha, D.; Lee, I.; Shrestha, S.; Acharya, S.; Nepal, P.; Gaire, B.; Fualo, V.; Sharma, S.D.; et al. Harnessing BiOI/V2O5 Nanocomposites: Advanced Bifunctional Catalysts for Visible-Light Driven Environmental Remediation and Antibacterial Activity. Molecules 2025, 30, 2500. https://doi.org/10.3390/molecules30122500
Pandey A, Gyawali N, Shrestha D, Lee I, Shrestha S, Acharya S, Nepal P, Gaire B, Fualo V, Sharma SD, et al. Harnessing BiOI/V2O5 Nanocomposites: Advanced Bifunctional Catalysts for Visible-Light Driven Environmental Remediation and Antibacterial Activity. Molecules. 2025; 30(12):2500. https://doi.org/10.3390/molecules30122500
Chicago/Turabian StylePandey, Anil, Narayan Gyawali, Devendra Shrestha, Insup Lee, Santu Shrestha, Subas Acharya, Pujan Nepal, Binod Gaire, Vince Fualo, Sabita Devi Sharma, and et al. 2025. "Harnessing BiOI/V2O5 Nanocomposites: Advanced Bifunctional Catalysts for Visible-Light Driven Environmental Remediation and Antibacterial Activity" Molecules 30, no. 12: 2500. https://doi.org/10.3390/molecules30122500
APA StylePandey, A., Gyawali, N., Shrestha, D., Lee, I., Shrestha, S., Acharya, S., Nepal, P., Gaire, B., Fualo, V., Sharma, S. D., & Hahn, J. R. (2025). Harnessing BiOI/V2O5 Nanocomposites: Advanced Bifunctional Catalysts for Visible-Light Driven Environmental Remediation and Antibacterial Activity. Molecules, 30(12), 2500. https://doi.org/10.3390/molecules30122500

